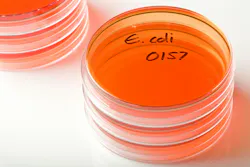
68ffa79cc8dafd83a179e971 E Coli 68ffa79cc8dafd83a179e971 E Coli

New research found that it is possible that nearly 1 in 5 UTIs in Southern California originated from strains of E coli that originated in food-producing animals. CIDRAP has the news.
The research team involved with the study “conducted molecular analysis of more than 5,700 extraintestinal pathogenic E coli (ExPEC) isolates collected from UTI patients and retail meat samples from stores in the neighborhoods where those patients lived.” They found that 18% of the UTIs were linked to ExPEC strains originating from the meat.
Most UTIs are mild, but “they can progress to more serious invasive infections and sepsis if the infection gets into the bloodstream.” ExPEC can get in the urinary tract and cause disease that way.
The investigators performed “whole-genome sequencing on 2,349 human clinical E coli isolates collected from KPSC regional labs from February 2017 through May 2021.” They also sequenced over 3,000 E coli isolates “collected from retail samples of chicken, turkey, beef, and pork that were bought weekly from major grocery chains in the region.” The model developed estimated that “17.7% of the human E coli isolates originated from food-producing animals, primarily chickens and turkeys. The researchers also found that a subset of E coli lineages, primarily those from poultry products, appeared to have ‘enhanced capacity’ to cause zoonotic UTIs.”
These zoonotic strains also tend to be less resistant to antibiotics. This finding may “support the effectiveness of efforts by the [FDA] to limit use of medically important antibiotics in livestock.” Additionally, “the highest proportion of zoonotic ExPEC isolates (21.5%) was identified in patients from high-poverty areas.”